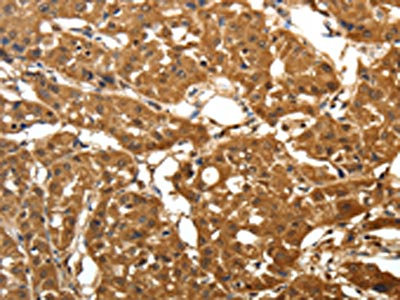

PARK7 Antibody
-
中文名稱:PARK7兔多克隆抗體
-
貨號:CSB-PA948689
-
規格:¥1100
-
圖片:
-
The image on the left is immunohistochemistry of paraffin-embedded Human lung cancer tissue using CSB-PA948689(PARK7 Antibody) at dilution 1/25, on the right is treated with fusion protein. (Original magnification: ×200)
-
The image on the left is immunohistochemistry of paraffin-embedded Human colon cancer tissue using CSB-PA948689(PARK7 Antibody) at dilution 1/25, on the right is treated with fusion protein. (Original magnification: ×200)
-
Gel: 12%SDS-PAGE, Lysate: 40 μg, Lane 1-2: Hela and Jurkat cell, Primary antibody: CSB-PA948689(PARK7 Antibody) at dilution 1/200 dilution, Secondary antibody: Goat anti rabbit IgG at 1/8000 dilution, Exposure time: 15 seconds
-
-
其他:
產品詳情
-
Uniprot No.:
-
基因名:
-
別名:CAP1 antibody; DJ-1 antibody; DJ1 antibody; DJ1 protein antibody; Epididymis secretory sperm binding protein Li 67p antibody; FLJ27376 antibody; FLJ34360 antibody; FLJ92274 antibody; HEL S 67p antibody; Oncogene DJ1 antibody; OTTHUMP00000001348 antibody; OTTHUMP00000001349 antibody; OTTHUMP00000001350 antibody; OTTHUMP00000001351 antibody; PARK7 antibody; PARK7_HUMAN antibody; Parkinson disease (autosomal recessive, early onset) 7 antibody; Parkinson disease protein 7 antibody; Parkinson protein 7 antibody; Protein DJ-1 antibody; SP22 antibody
-
宿主:Rabbit
-
反應種屬:Human,Mouse,Rat
-
免疫原:Full length fusion protein
-
免疫原種屬:Homo sapiens (Human)
-
標記方式:Non-conjugated
-
抗體亞型:IgG
-
純化方式:Antigen affinity purification
-
濃度:It differs from different batches. Please contact us to confirm it.
-
保存緩沖液:-20°C, pH7.4 PBS, 0.05% NaN3, 40% Glycerol
-
產品提供形式:Liquid
-
應用范圍:ELISA,WB,IHC
-
推薦稀釋比:
Application Recommended Dilution ELISA 1:1000-1:2000 WB 1:200-1:1000 IHC 1:50-1:200 -
Protocols:
-
儲存條件:Upon receipt, store at -20°C or -80°C. Avoid repeated freeze.
-
貨期:Basically, we can dispatch the products out in 1-3 working days after receiving your orders. Delivery time maybe differs from different purchasing way or location, please kindly consult your local distributors for specific delivery time.
-
用途:For Research Use Only. Not for use in diagnostic or therapeutic procedures.
相關產品
靶點詳情
-
功能:Multifunctional protein with controversial molecular function which plays an important role in cell protection against oxidative stress and cell death acting as oxidative stress sensor and redox-sensitive chaperone and protease. It is involved in neuroprotective mechanisms like the stabilization of NFE2L2 and PINK1 proteins, male fertility as a positive regulator of androgen signaling pathway as well as cell growth and transformation through, for instance, the modulation of NF-kappa-B signaling pathway. Has been described as a protein and nucleotide deglycase that catalyzes the deglycation of the Maillard adducts formed between amino groups of proteins or nucleotides and reactive carbonyl groups of glyoxals. But this function is rebuted by other works. As a protein deglycase, repairs methylglyoxal- and glyoxal-glycated proteins, and releases repaired proteins and lactate or glycolate, respectively. Deglycates cysteine, arginine and lysine residues in proteins, and thus reactivates these proteins by reversing glycation by glyoxals. Acts on early glycation intermediates (hemithioacetals and aminocarbinols), preventing the formation of advanced glycation endproducts (AGE) that cause irreversible damage. Also functions as a nucleotide deglycase able to repair glycated guanine in the free nucleotide pool (GTP, GDP, GMP, dGTP) and in DNA and RNA. Is thus involved in a major nucleotide repair system named guanine glycation repair (GG repair), dedicated to reversing methylglyoxal and glyoxal damage via nucleotide sanitization and direct nucleic acid repair. Protects histones from adduction by methylglyoxal, controls the levels of methylglyoxal-derived argininine modifications on chromatin. Able to remove the glycations and restore histone 3, histone glycation disrupts both local and global chromatin architecture by altering histone-DNA interactions as well as histone acetylation and ubiquitination levels. Displays a very low glyoxalase activity that may reflect its deglycase activity. Eliminates hydrogen peroxide and protects cells against hydrogen peroxide-induced cell death. Required for correct mitochondrial morphology and function as well as for autophagy of dysfunctional mitochondria. Plays a role in regulating expression or stability of the mitochondrial uncoupling proteins SLC25A14 and SLC25A27 in dopaminergic neurons of the substantia nigra pars compacta and attenuates the oxidative stress induced by calcium entry into the neurons via L-type channels during pacemaking. Regulates astrocyte inflammatory responses, may modulate lipid rafts-dependent endocytosis in astrocytes and neuronal cells. In pancreatic islets, involved in the maintenance of mitochondrial reactive oxygen species (ROS) levels and glucose homeostasis in an age- and diet dependent manner. Protects pancreatic beta cells from cell death induced by inflammatory and cytotoxic setting. Binds to a number of mRNAs containing multiple copies of GG or CC motifs and partially inhibits their translation but dissociates following oxidative stress. Metal-binding protein able to bind copper as well as toxic mercury ions, enhances the cell protection mechanism against induced metal toxicity. In macrophages, interacts with the NADPH oxidase subunit NCF1 to direct NADPH oxidase-dependent ROS production, and protects against sepsis.
-
基因功能參考文獻:
- DJ-1 protein concentration was significantly increased during the clinical phase in cerebrospinal fluid of sporadic Creutzfeldt-Jakob disease patients. PMID: 27975168
- The Parkinsonism-associated protein DJ-1 and its bacterial homologs deglycase 1/Hsp31, deglycase 2/YhbO, and deglycase 3/YajL function as deglycases that repair proteins and nucleotides from endogeneous glycation by glyoxal and methylglyoxal. DJ-1, deglycase 1 and deglycase 2 repair glyoxal- and methylglyoxal-glycated substrates, whereas deglycase 3 principally repairs glyoxal-glycated substrates. PMID: 29932913
- Data of this study showed that DJ-1 downregulation increased apoptosis and reduced migration by regulating matrix metalloproteinase 2 and matrix metalloproteinase 9 in HTR-8/SVneo cells under both ambient and oxidative stress. PMID: 29258409
- NRF2, DJ1 and SRNX1 are commonly expressed in diffusely infiltrating astrocytomas and they can be used in predicting patient prognosis. PMID: 29441509
- Low PARK7 expression is associated with pre-term birth. PMID: 29358306
- The results suggest that the impaired mitochondrial activity could be due to the broken interaction between DJ-1 and NDUFS3 and that downregulation of DJ-1 in sperm and testes contributes to AS pathogenesis. PMID: 29849492
- In this review, we discuss the role as well as the underlying molecular mechanisms of DJ-1 in ocular diseases, including Fuchs endothelial corneal dystrophy (FECD), age-related macular degeneration (AMD), cataracts, and ocular neurodegenerative diseases, highlighting that DJ-1 may serve as a very striking therapeutic target for ocular diseases. PMID: 29559831
- Novel candidate genes of the PARK7 interactome play a role in MS. PMID: 29100048
- results indicated that oxDJ-1 levels in erythrocytes can be used as a marker for the differential diagnosis of Parkinson's disease PMID: 28705587
- DJ-1 promoter polymorphism is associated with male infertility. PMID: 28932933
- The PD-associated L166P mutant, but not wild-type DJ-1, directly binds to and is cleaved by the mitochondrial serine protease Omi at both serine residues 3 and 121. PMID: 29177768
- DJ-1 plays a major role in various signaling pathways. Related to its anti-oxidant properties, it mediates cell survival and proliferation by activating the extracellular signal-regulated kinase (ERK1/2) pathway and attenuates cell death signaling by inhibiting apoptosis signal-regulating kinase 1 (ASK1) activation. [review] PMID: 28954246
- the present study highlighted the involvement of DJ1 in HGrelated EC injury and identified that DJ1 exerts a cellular protective effect in HUVECs exposed to HG induced oxidative stress via activation of the PI3K/AkteNOS signaling pathway. PMID: 29115508
- These findings suggest that oxidation-induced ubiquitination and degradation can be a quality control mechanism of oxidized redox-sensitive proteins including Prxs and DJ-1. PMID: 27703196
- study implies that DJ-1 may protect endothelial progenitor cells against Ang II-induced dysfunction by activating the PPARgamma/HO-1. PMID: 28600848
- Study shows the generation of oxDJ-1 in erythrocytes in early stage, unmedicated parkinson's disease (PD) patients and in non-human primates with PD symptoms. In addition, oxDJ-1 interacts with 20S proteasome in the erythrocytes of PD patients. The current findings suggest that oxidative stress is systemically present in PD patients and suggest that an early pathophysiological mechanism operates in PD. PMID: 27470541
- Not only is protein deglycase DJ-1 (DJ-1) linked to familial Parkinson's disease (PD), but it is also associated with the pathogenic mechanisms of sporadic PD and other neurodegenerative disorders where oxidative stress is implicated [Review]. PMID: 29147901
- Studies indicate that protein deglycase DJ-1 (DJ-1) plays a critical role in cancer [Review] PMID: 29147902
- Studies indicate that sperm protein deglycase DJ-1 (DJ-1 concentration in Asthenozoospermia is lower than that in control. PMID: 29147903
- Studies indicate Cys-106-oxidized protein deglycase DJ-1(oxDJ-1) levels in the brain and blood as a biomarker candidate for early-phase Parkinson's disease. PMID: 29147908
- Data suggest that protein deglycase DJ-1 (DJ-1) plays multiple roles in many cell types under metabolically challenging conditions as seen in obesity, insulin resistance, and type 2 diabetes mellitus [Review]. PMID: 29147909
- Studies suggest that protein deglycase DJ-1 (DJ-1) plays a critical role in tumor development and progression, and also as a therapeutic target against cancer. PMID: 29147911
- The clinical pattern of multisystem involvement and the biochemical findings in our patient highlight the role for DJ-1 in modulating mitochondrial response against oxidative stress. PMID: 27460976
- Oxidised DJ-1 was significantly decreased in idiopathic PD brain, suggesting altered complex function may also play a role in the more common sporadic form of the disease. PMID: 29016861
- High DJ1 expression is associated with breast cancer. PMID: 27582551
- Three types of pathogenic mutants of DJ-1 (M26I, D149A and L166P) have been reported to disrupt proper structures and lead to a loss of function--{REVIEW} PMID: 28458339
- the results suggest that over-oxidation may trigger loss of functions due to local structural modification in the Cys106 containing pocket of DJ-1 and structurally destabilize the dimeric state of DJ-1, which is believed to be its bioactive conformation. Such loss of functions would result in reduced ability of DJ-1 to protect from oxidative stress insults and may lead to increased progression of disease. PMID: 28844983
- This study demonstrated that the DJ1 mutations account for approximately 5% of EOPD patients from the Indian population. PMID: 27592010
- This report describe a new homozygous c.133C > T transition in DJ1 segregating with PD and ALS in a family from eastern Turkey. PMID: 26972524
- SiRNA-mediated DJ-1 knockdown reduced myeloma cell growth under a hypoxic microenvironment. PMID: 27734217
- chaperone-mediated autophagy protects mitochondrial function by degrading nonfunctional PARK7 and maintaining its homeostasis, and dysregulation of this pathway may contribute to the neuronal stress and death in Parkinson disease pathogenesis PMID: 27171370
- DJ-1 and its prokaryotic homologs constitute a major nucleotide repair system named guanine glycation repair. PMID: 28596309
- Taken together, our results provide a structural basis for the binding mechanism between DJ-1 and Bcl-XL, which will contribute to molecular understanding of the role of mitochondrial DJ-1 in Bcl-XL regulation in response to oxidative stress. PMID: 29175327
- Results suggest that overexpression of DJ-1 improves mitochondrial function, at least in part, through a mechanism involving Akt phosphorylation on threonine 308. PMID: 26913805
- Hsp31 is a homodimeric protein structurally similar to human DJ-1, a Parkinson's disease-linked protein, and both are members of the DJ-1/ThiJ/PfpI superfamily. PMID: 27097320
- DJ-1 co-aggregating with alpha-synuclein may result from weak hydrophobic interaction and DJ-1 exhibited chaperon-like activity in the initial time of alpha-synuclein aggregation at high temperature. PMID: 28330770
- The effects of variants in the Parkin, PINK1, and DJ-1 genes along with evidence for their pathogenicity have been summarized. (Review) PMID: 26965687
- genetic analyses of indel loci in ACE, DJ-1, and GIGYF2 genes, was performed to explore the potential contribution of insertion (I)/deletion (D) polymorphisms (indels) to the risk of PD in a Chinese population. PMID: 28873462
- DJ-1 deficiency negatively regulates liver progenitor cells (LPC) proliferation by impairing the formation of LPC-associated fibrosis and inflammatory niches. PMID: 27277679
- Downregulation of DJ-1 using DJ-1-siRNA in H69AR cells sensitized cancer cells to chemotherapeutic drugs through increasing drug-induced cell apoptosis accompanied with G0-G1 phase arrest. These findings suggest DJ-1 may serve as a potential biomarker for chemoresistance and prognostic factor for patients with small-cell lung cancer (SCLC). PMID: 28580701
- regulation of reactive oxygen species (ROS) and of the antioxidant protein DJ-1 (PARK-7), which increases with cancer progression and acts to lessen oxidative damage to malignant cells, in relationship with systemic mastocytosis severity, was examined. PMID: 27611333
- DJ-1 was highly expressed in the early stage of lung cancer, and its expression was significantly decreased after metastasis. Therefore, DJ-1 may be a potential biomarker for the early diagnosis and monitoring of lung cancer metastasis PMID: 28653888
- DJ-1 overexpression can restore the impaired Nrf2 pathway, leading to Alveolar type II cell protection in heavy smokers. PMID: 27093578
- DJ-1 serum levels seem to be correlated with worsening of the endometrial cancer grade and histotype, making it a reliable tool in the preoperative decision-making process. PMID: 28618925
- DJ-1 family deglycases repair proteins from glycation by glyoxals. Contradictory results suggested that this activity resulted from a Tris artefact. We show here that DJ-1 behaves indeed as a bona fide deglycase. PMID: 28013050
- ELISA-based detection of flotillin 2 and PARK7 showed that the combination of these proteins was able to distinguish prostate cancer patients and healthy controls with 68% sensitivity and 93% specificity PMID: 27664330
- Furthermore, SIRT1 activity was reduced in DJ-1-knockout cells, and this reduced activity was restored by re-introduction of wild-type DJ-1 but not of C106-mutant DJ-1 into DJ-1-knockout cells. It is first report showing direct connection of DJ-1 with SIRT1. PMID: 27105916
- DJ-1 is necessary for 20C-mediated protection against rotenone-induced oxidative damage, at least in part, by activating PI3K/Akt signaling, and subsequently enhancing the nuclear accumulation of Nrf2. PMID: 28245986
- The aberrant up-regulation of DJ-1 expression might be an important step in the pathogenesis of cervical carcinoma. PMID: 27544688
- Association of early onset Parkinson' and severe clinical signs with multiple alterations in DJ1 in Turkish patients. PMID: 27455133
顯示更多
收起更多
-
相關疾病:Parkinson disease 7 (PARK7)
-
亞細胞定位:Cell membrane; Lipid-anchor. Cytoplasm. Nucleus. Membrane raft. Mitochondrion. Endoplasmic reticulum.
-
蛋白家族:Peptidase C56 family
-
組織特異性:Highly expressed in pancreas, kidney, skeletal muscle, liver, testis and heart. Detected at slightly lower levels in placenta and brain (at protein level). Detected in astrocytes, Sertoli cells, spermatogonia, spermatids and spermatozoa. Expressed by panc
-
數據庫鏈接:
Most popular with customers
-
-
YWHAB Recombinant Monoclonal Antibody
Applications: ELISA, WB, IHC, IF, FC
Species Reactivity: Human, Mouse, Rat
-
Phospho-YAP1 (S127) Recombinant Monoclonal Antibody
Applications: ELISA, WB, IHC
Species Reactivity: Human
-
-
-
-
-